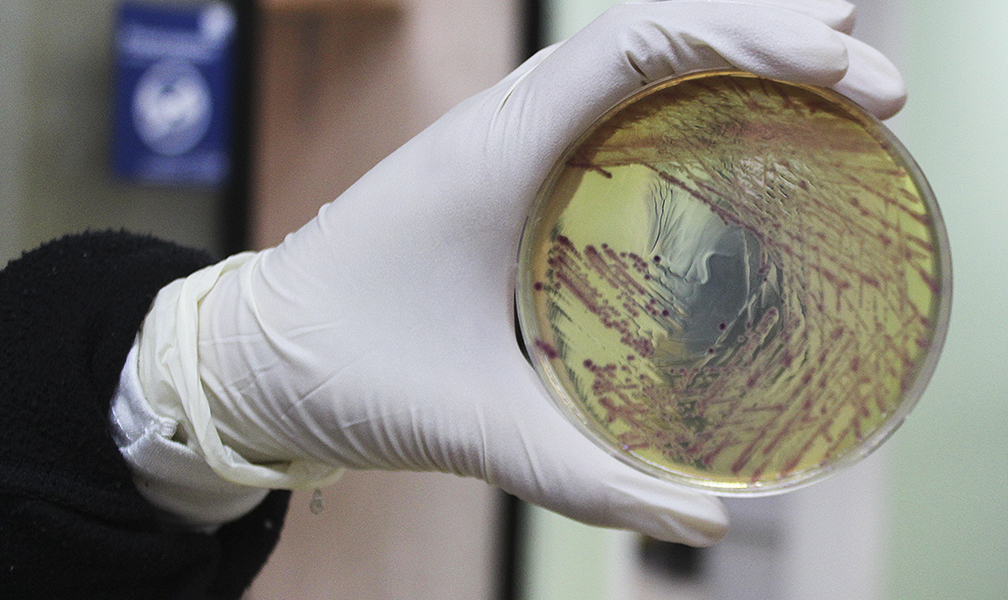

VISIÓN
: SER EL LABORATORIO LIDER A NIVEL REGIONAL, CON LA MÁS AMPLIA DIVERSIDAD DE EXÁMENES AVALADO POR LA CALIDAD ANALITICA DE NUESTROS PROCESOS Y EL RESPALDO DE LA COMUNIDAD
MISIÓN
OTORGAR A NUESTROS CLIENTES EXAMENES CONFIABLES, CONFIENCIALES Y OPORTUNOS QUE CONTRIBUYEN AL RESTABLECIMIENTO DE LA SALUD Y CON ELLO CUMPLIR CON LAS EXPECTATIVAS DE LOS MEDICOS Y PACIENTES DE LA CIUDAD.